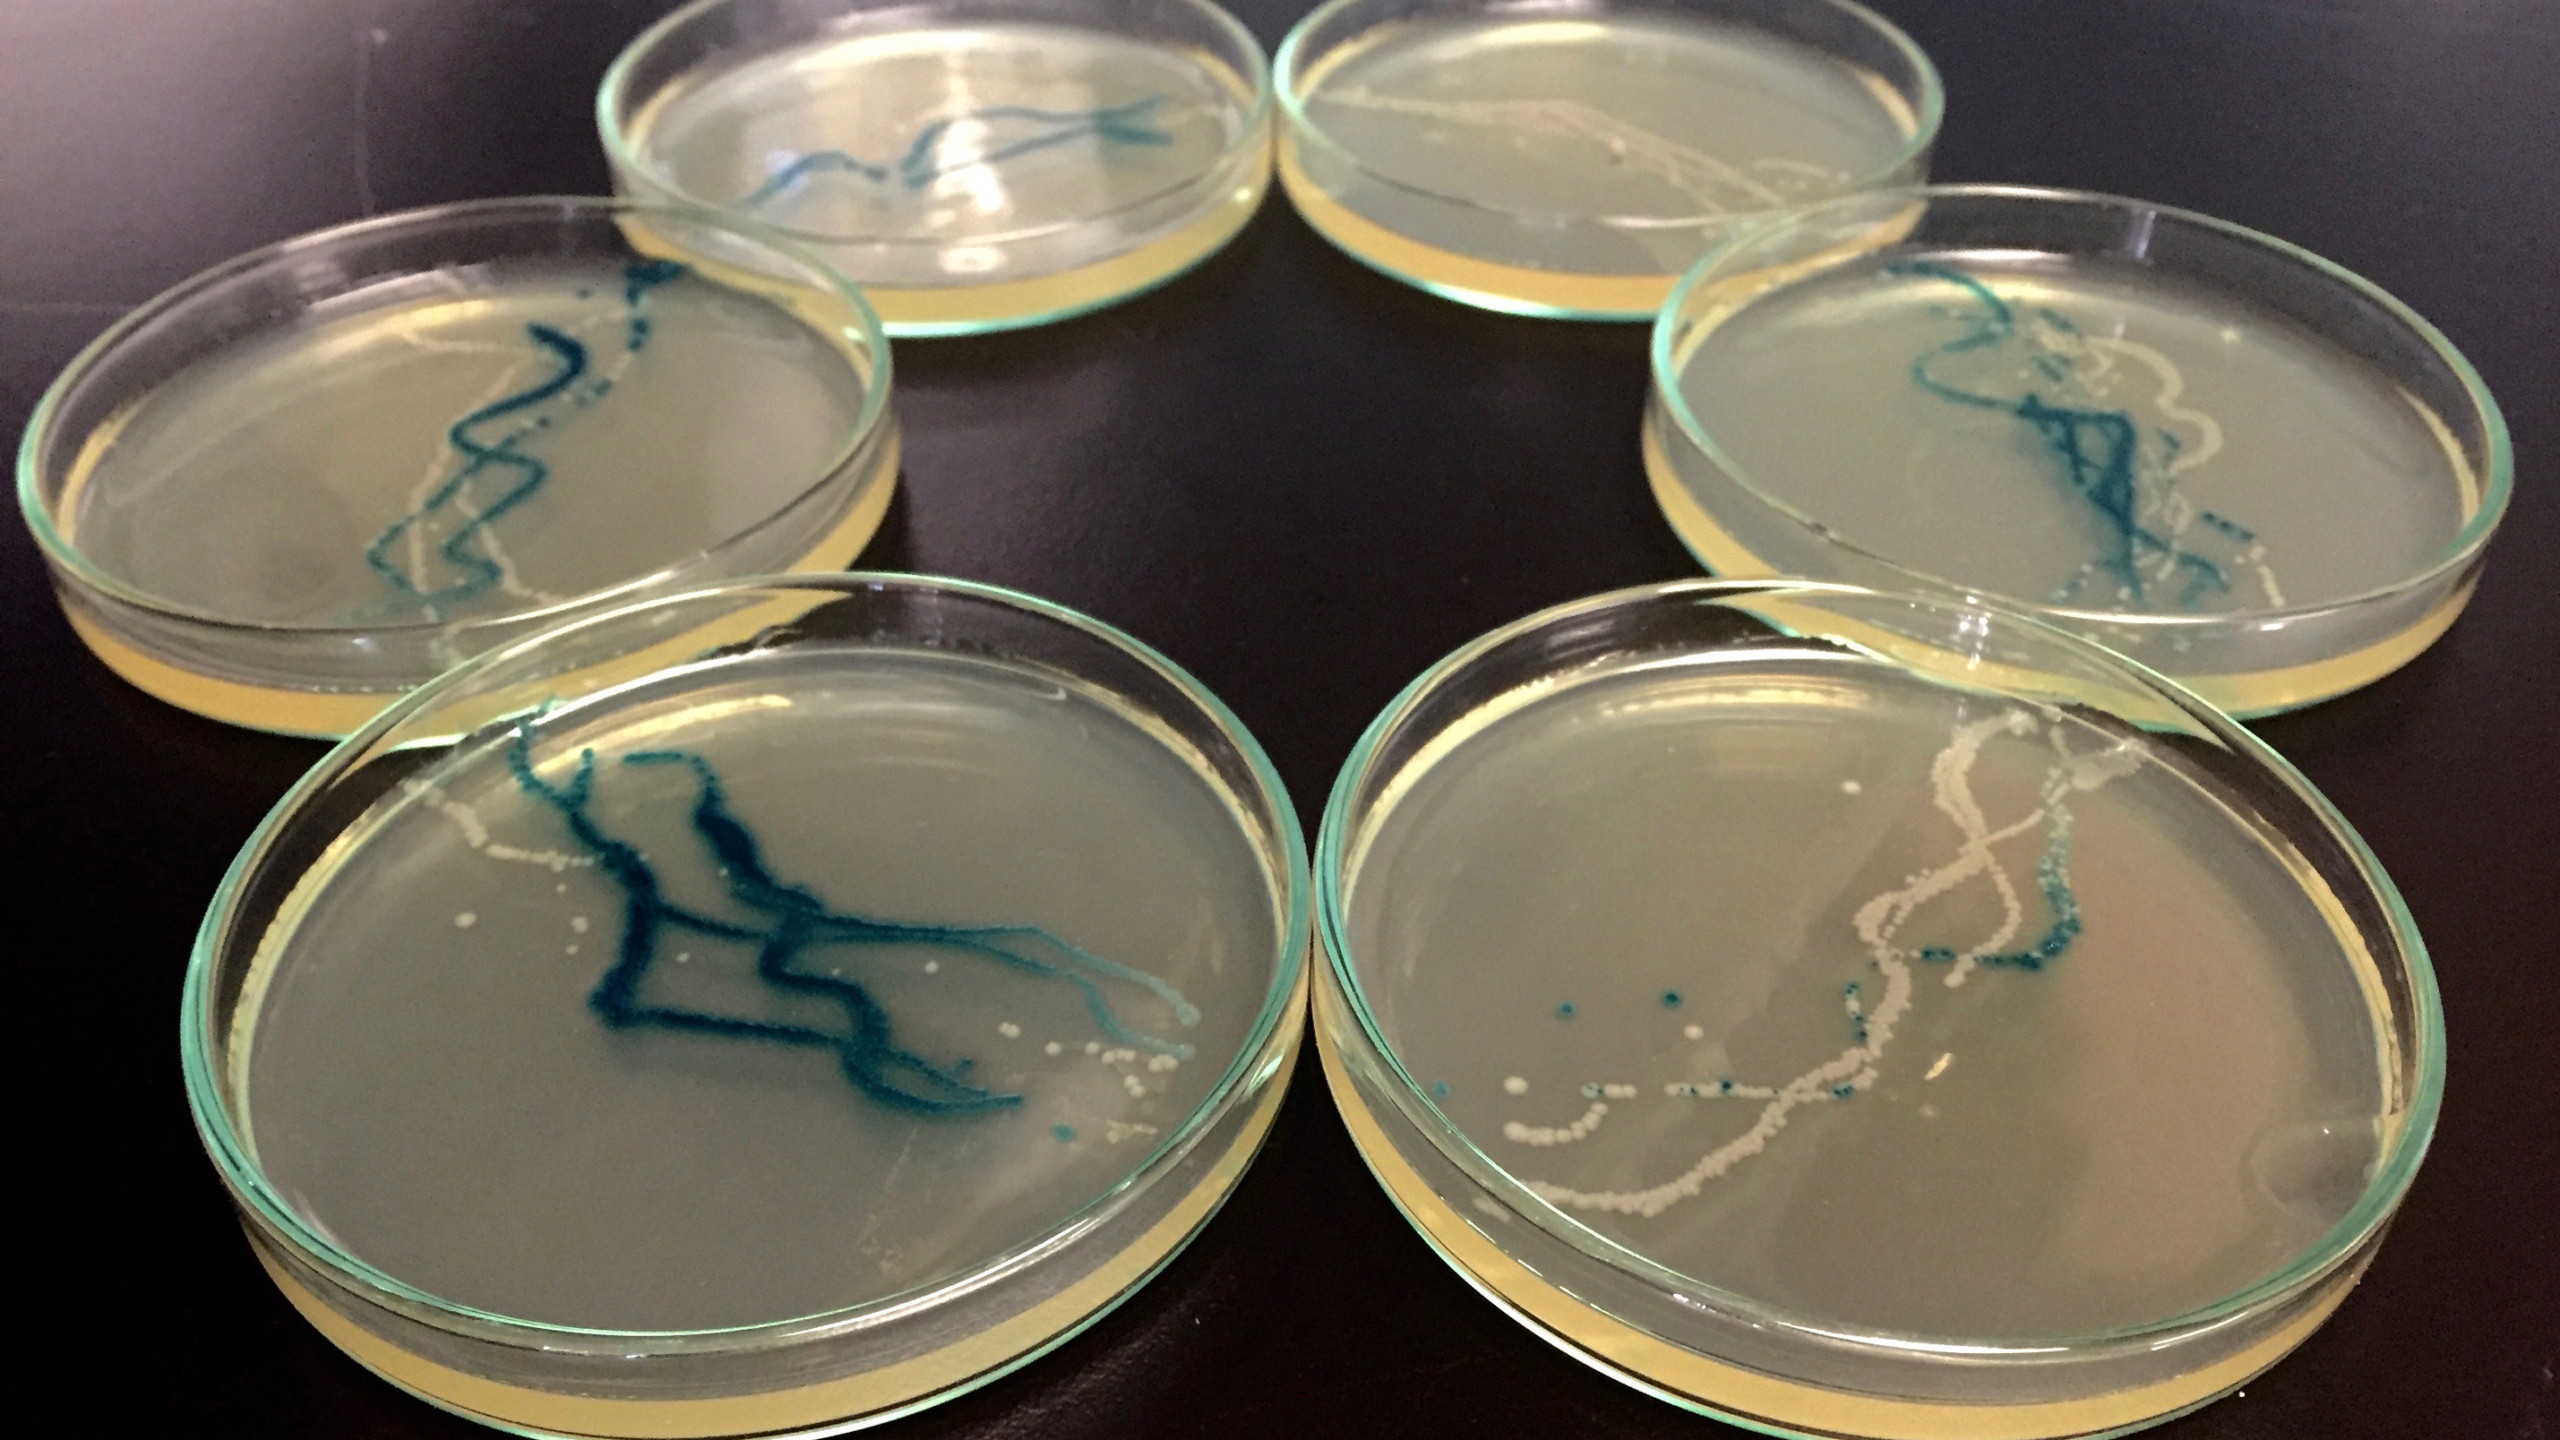

Art et agentivité à l’heure du wetware

- Publié le 18 novembre 2017
- Jens Hauser
- 10 minutes
Face à l’interrogation obsessionnelle sur la nature de la vie, l’art a tenté de comprendre et recréer le vivant, développant le mythe de la « vivification » et une fascination pour la mise en scène du vivant. Ayant toujours cherché à imaginer, représenter, imiter puis simuler le vivant, il en arrive désormais à la manipulation directe par le wetware. Si les technologie de l’information avaient données dans les années 1970 une nouvelle direction à l’art, au profit des processus dynamiques plutôt que les objets, la convergence de la biologie de synthèse et des technologies du vivant permet désormais d’explorer ce wetware, des « machines humides » qui estompent les frontières entre organismes et machines. La création de « vie artificielle » dépasse la simulation informatique et la robotique, donnant naissance à des systèmes hybrides et semi-vivants qui remettent en cause les frontières entre le vivant et le non-vivant, la vie synthétique et la vie organique. Pour l’Artificial life art, la simulation et la re-matérialisation organique ne sont plus distinctes mais des opérations compatibles avec le wetware, déplaçant les concepts d’art, d’agentivité et d’animation.
« Ces robots ne sont pas conscients », insista Maman. Elle avait bu beaucoup de vin rouge dans la cuisine, et, à présent, ils étaient tous (de nouveau) au champagne. « Rien de plus qu’une bande de machines, bordel. » « Toi aussi, tu es une machine, Tante Amy, lâcha Willy. La seule différence, c’est que tu es faite de chair, et eux de câbles et de silicone. »
Si les artistes ont déjà mis en scène des « vies artificielles » par le biais du hardware, du software et de la robotique, simulant des systèmes vivants, avec la convergence de la biologie de synthèse et des technologies du vivant, la notion s’est aujourd’hui déplacée vers le wetware. L’influence de la technologie de traitement de l’information atteint clairement un nouveau niveau avec les « machines humides » fabriquées par l’homme. D’autre part, les capacités technologiques innées aux organismes présumés primitifs et aux systèmes biologiques ancestraux sont actuellement reconsidérées dans leur complexité, que l’esprit humain ne commence que lentement à comprendre : les bactéries, les microbiomes, le phytoplancton et les extrêmophiles sont aujourd’hui étudiés sous l’angle de leurs agentivités propre et de leurs potentiels à synthétiser. Avec le terme wetware comme outil discursif transdisciplinaire, les notions d’art, d’agentivité et d’animation [Art, Agency and Animation] prennent ainsi de nouvelles significations, qui se sont récemment traduites par une exposition éponyme au Beall Center for Art & Technology de l’Université de Californie, à IrvineL’exposition Wetware: Art, Agency, Animation, co-organisée par l’auteur Jens Hauser et David Familian, a présenté les œuvres de Adam Brown, Gilberto Esparza, Thomas Feuerstein, Klaus Spiess et Lucie Strecker, Orkan Telhan, Evelina Domnitch et Dmitry Gelfand, et Anna Dumitriu, du 6 février au 7 mai 2016.. Dans le contexte des avant-gardes américaines du XXe siècle, Wetware: Art, Agency, Animation faisait écho et proposait un update de SoftwareBurnham, Jack: Software. Information Technology: Its New Meaning for Art. New York, 1970.l’exposition fondatrice de Jack Burnham, qui examinait en 1970 le nouveau sens pour l’art des technologies de l’information, pointant déjà une évolution des préoccupations artistiques vers les systèmes naturels et artificiels, les processus dynamiques plutôt que les objets, mais aussi l’importance des relations écologiques.
La question « Qu’est-ce que la vie ? » comme son extension logique « Qu’est-ce que la vie artificielle ? » constituent des interrogations récurrentes de l’histoire culturelle, incarnées par nos tentatives de comprendre – philosophiquement, scientifiquement et artistiquement – et de recréer ce qui constitue réellement le vivant. Dans nos efforts pour appréhender les caractéristiques intrinsèques qui font que les êtres vivants sont vivants, la reconstruction et la recréation de synthèse – à partir de l’analyse – semblent être une constante quête humaine. Bien qu’il n’y ait aucune preuve que l’humanité comprenne vraiment ce qu’elle crée, certains considèrent la fabrication de synthèse comme la réalisation ultime de la connaissance, citant le mantra du physicien américain Richard Feynman : « Ce que je ne peux pas créer, je ne le comprends pas » – phrase significativement prononcée l’année même de la parution de Wetware, roman de science-fiction biopunk de Rudy Rucker, dans lequel une race de robots intelligents crée des hybrides synthétiques-organiques appelés « meatbops »Rucker, Rudy: Wetware. New York, 1988..
Synthèse humide
« Qu’est-ce que la vie artificielle » aujourd’hui ? L’attirail du laboratoire humide est de retour, et nous constatons un vif intérêt de l’art pour les systèmes hybrides et semi-vivants, avec un accent particulier mis sur les projets qui remettent en question les frontières entre le vivant et le non-vivant, la vie synthétique et la vie organique, y compris la vie basée sur le carbone manipulé. Les philosophes scientifiques tels que Marc A. Bedau, rédacteur en chef de la revue internationale Artificial Life, suggèrent que les recherches de la biologie de synthèse – comme les cellules artificielles qui nettoient l’environnement ou produisent des carburants de substitution, ou encore les tentatives de synthèse ex nihilo de protocellulesRasmussen, Steen, et al. (ed.): Protocells. Bridging Nonliving and Living Matter. Cambridge/Londres, 2009. – constituent aujourd’hui des cas de vie artificielle « humide ». Cela mettrait ainsi un terme à la vieille querelle de savoir si la vie artificielle in silico peut être littéralement vivante, ou si elle n’est qu’une simulation ou représentation. Dans un article intitulé de façon provocante What is Life? – en référence au célèbre texte d’Erwin Schrödinger de 1944 Schrödinger, Erwin: What is life? The Physical Aspect of the Living Cell. Cambridge, 1944. –, Bedau avance que « la vie artificielle soft a créé des systèmes de software étonnamment proches de la vie, au point de paraître véritablement vivants pour certains, tandis que d’autres continuent à soutenir qu’il est ridicule de penser qu’une simulation par ordinateur puisse être littéralement vivante ». Bedau, Mark A.: What is Life? In: Sarkar, Sahotra and Plutynski, Anya (ed.): A Companion to the Philosophy of Biology. New York, 2007, p. 455. Par ailleurs, la version dure de la vie artificielle humide est intuitivement plausible ; nous acceptons généralement sans trop de problème qu’une chose synthétisée ex nihilo en laboratoire puisse être littéralement vivante. Ibid., p. 460.
La biologie de synthèse est désormais perçue comme une discipline oscillant entre des approches ascendantes et descendantes mais également entre le virtuel et le réel. La simulation et la mise en œuvre de matériau organique ne sont plus considérées comme des méthodes antagonistes, mais compatibles. La discipline a pour objectif d’appliquer des principes d’ingénierie à la biologie, de façon à modifier mais surtout construire « la vie » à partir de rien, de concevoir des « machines vivantes ». Lors de la synthèse de l’ADN, l’information génétique est produite chimiquement et transférée dans des cellules étrangères ; des organismes peuvent être équipés de nouvelles fonctions via des circuits biologiques à base d’ADN ; les recherches en organismes minimaux étudient des unités biologiques réduites à leurs fonctions de survie ; des protocellules, premiers stades de vie cellulaire, peuvent être produites à partir de substances chimiques inertes ; la xénobiologie construit des systèmes biologiques fonctionnels qui n’existent pas dans la nature et n’ont d’ailleurs pas vocation à interagir avec elleSchmidt, Markus, (ed.): Synthetic Biology. Industrial and Environmental Applications. Weinheim, 2012..
Pour l’Artificial life art, cela signifie que la simulation et la re-matérialisation organique ne peuvent plus être considérées comme distinctes, mais bien comme des opérations compatibles avec le wetware. Les artistes qui intègrent ou créent des laboratoires sont particulièrement « proches de la vie » dans un sens biologique littéral, et en parallèle la biologie de synthèse est bien placée pour moderniser les paradigmes historiques de la « création » en art. La démocratisation des outils de laboratoire a par ailleurs mené à leur détournement par des bricoleurs et activistes des nouveaux médias, qui appliquent le potentiel de la culture open source de l’ère numérique à la biologie Do It Yourself. Avec la convergence progressive du hardware, software et wetware, des « wet corners », laboratoires de fortunes, sont mis en place dans des hacker spaces ou locaux de collectifs d’artistes médias, souvent d’après un modèle créatif et politique d’appropriation initié par les associations de cinéma Super 8, les vidéo-clubs, les radios libres ou la philosophie du mouvement des hackers.
C’est dans ce contexte qu’intervient l’exposition Wetware, avec ses résidences artistiques associées. Elle présente des artistes qui repoussent les limites de leur travail vers des pratiques rendues possibles par les technologies contemporaines. Ils ne s’agit pas simplement d’illustrer les innovations techniques : ces artistes bouleversent littéralement la fonction utilitaire du wetware. En matérialisant des « machines vivantes » dépassant la simple simulation, ils défient les systèmes et outils expérimentaux au-delà de leur utilité pratique dans les sciences naturelles pour questionner les grandes métaphores qui les sous-tendent. Wetware juxtapose des projets artistiques qui étudient, de manière créative et critique, la vision anthropocentrique derrière la conception de vies artificielles humides, et les responsabilités qui en découlent. Les concepts d’art, d’agentivité et d’animation sont ainsi déplacés. L’art sort de la cage dorée du symbolisme et s’engage dans des processus techno-scientifiques qui façonnent les visions du monde contemporaines. L’agentivité n’est plus réservée aux seuls êtres humains, mais tout autant attribué aux formes de vie non-humaines, machines ou systèmes expérimentaux. Le concept d’animation – au sens courant « créer des films ou des effets spéciaux » – revient à sa signification première : la qualité et condition d’être vivant, ou d’être rendu vivant ou semblable à la vie.

Technicité primitive et encapsulations animées
Cependant, en essayant de prédire « Qu’est-ce que sera la vie ? » à l’avenir, nous devrions considérer non seulement la standardisation et la modularisation d’unités abstraites similaires au hardware et au software, transposées au wetware, mais pourrions également nous demander – comme le fait l’anthropologue Stefan Helmreich – « Ce qu’était la vie ? »Helmreich, Stefan : What Was Life? Answers from Three Limit Biologies. Dans : Critical Inquiry, Vol. 37, No. 4 (Été 2011), p. 671-696.. Découvririons-nous l’avenir des formes de vie possibles dans l’histoire de l’émergence de la vie selon ce que Helmreich nomme les « biologies limites » ? Si la « vie », en tant que concept, est avant tout « un modèle transposable à travers les médiasIbid, p. 676. », examinons de plus près les écologies extrêmes de la vie océanique, telles que le phytoplancton, ou encore à la capacité des bactéries à survivre dans des conditions extrêmes : « Des biologies limites, comme ‘‘la vie artificielle’’, la biologie marine extrême et l’astrobiologie soulignent des instabilités importantes dans les concepts de nature – organique, terrestre ou cosmiqueIbid, p. 677. » – et du vivant en tant que tel. De plus, on trouvera à ces extrêmes toute une gamme de phénomènes qui peuvent être considérés comme les capacités techniques innées des micro-organismes lorsqu’ils sont « poussés aux limites de ce que les biologistes croyaient possiblesIbid, p. 683. » – révélant une « nature » qui crée et synthétise elle-même, pour ainsi dire, par exemple des bactéries évoluant pour manger du plastique et autres déchets d’origine humaine.
L’art du wetware incarne et matérialise poétiquement ces questions philosophiques et épistémologiques. La pratique artistique de l’artiste mexicain Gilberto Esparza explore ainsi symboliquement la vie comme un modèle transposable à travers les médias, déplaçant les notions de vie artificielle du domaine mécanique, électronique et informatique au domaine organique, d’où elles sont originaires. Le visiteur découvre des mouches défendant leur espace vital en dessinant des cercles concentriques de leurs inépuisables rotors motorisés, attachés à des fils électriques. Des chenilles géantes se font les dents sur des câbles téléphoniques, creusant leur chemin en entravant les télécommunications, tandis que des « multipeds », organismes robotisés aux torses cylindriques et aux membres délicats éliminent le gaspillage de la civilisation urbaine – tous ces « parasites » à base de software et de hardware étant exclusivement composés de déchets technologiques humains. BioSoNot, se présente quant à elle comme un synthétiseur musical qui permet aux hommes d’entendre les oscillations électriques de bactéries nettoyant de l’eau contaminée dans des piles microbiennes – Esparza n’utilise d’ailleurs que des bactéries autochtones, qui « synthétisent naturellement », et non des bactéries artificielles. Dans la même veine, Great Work of the Metal Lover, d’Adam Brown, héberge des bactéries extrêmophiles souvent utilisées pour assainir des sols industriels contaminés aux métaux toxiques. Elles produisent ce faisant de l’or, résolvant, en apparence, le mystère de la pierre philosophale. De telles œuvres d’art procédurales expriment moins l’« autonomie » ou l’« intelligence » qui étaient souvent revendiquées aux débuts de l’Artificial Life Art – pour décrire l’imitation de la cognition humaine –, que l’intelligence décentralisée et collaborative mise en œuvre par ces systèmes pour nettoyer les déchets de l’humanité en période de crises écologiques et climatiques majeures.

Alors que la maladie de Panama menace les bananes Cavendish, Orkan Telhan construit son Microbial Design Studio – un comptoir wetlab destiné à créer des bactéries susceptibles de reproduire l’odeur et le goût de ces bananes dans des encapsulations semi-vivantes. Luminiferous Drift, l’installation live d’Evelina Domnitch et Dmitry Gelfand, explore un autre type d’encapsulation. Des formes de vie artificielle mimant des protocellules – modèles de cellules formées par une chimie innée complexe – permettent de simuler visuellement les mouvements physiques du phytoplancton dans une biosphère, comme vue de l’espace, matérialisant ainsi à une échelle miniature mais de façon saisissante la fragilité de nos écosystèmes. Chaque « biologie limite » en entraîne une autre, dans une interaction d’acteurs non humains, réalisant le spectacle éblouissant de ce que l’on pourrait appeler la microperformativitéHauser, Jens: Molekulartheater, Mikroperformativität und Plantamorphisierungen. Dans : Stemmler, Susanne (ed.): Wahrnehmung, Erfahrung, Experiment, Wissen. Objektivität und Subjektivität in den Künsten und den Wissenschaften. Zürich/Berlin, 2014, p. 173-189..
Microperformativité et macropréoccupations
Dans les mises en scènes biotechnologiques de Klaus Spiess et Lucie Strecker, la microperformativité joue également un rôle central. Pour Hare’s Blood +, un « animal moléculaire » a été conçu sous la forme d’une biobrick artistique, séquence génétique standard augmentée de séquences de gènes isolées du sang du célèbre lièvre de Joseph Beuys, retournant ainsi l’utopie de l’artiste et l’engagement politique de sa performance pour une contre-économie équitable à la lumière de la spéculation autour de la bio-économie. Les bactéries artificielles sont les protagonistes de Pancreas, la sculpture biotechnologique de Thomas Feuerstein, qui relève du wetware au sens le plus littéral du terme, celui utilisé en science-fiction, dénotant des éléments fonctionnels équivalents à ceux d’un ordinateur dans les systèmes biologiques ou chez une personne – ici, dans le cerveau humain. Feuerstein se réfère à une autre connotation du wetware, à savoir que, « par rapport au hardware et au software, le wetware est un composant légèrement dysfonctionnel, une source d’erreurs, [et] peut être nettement inférieur, même si certains de ses aspects intérieurs sont – toujours – inatteignables par le hardware et le software ».Winthrop-Young, Geoffrey: Hardware/Software/Wetware. Dans : Mitchell, W.J.T. and Hansen, Mark B. N. (ed.): Critical Terms for Media Studies. Chicago/Londres, 2010, p. 191. Touchant au statut du cerveau, entre spiritualisme et métabolisme, l’artiste nourrit des cellules neurologiques humaines avec du glucose afin qu’elles se développent à l’image d’un cerveau humain, et cela par des bactéries spécialement modifiées pour produire du glucose à partir de la cellulose de livres déchiquetés. Le régime alimentaire du cerveau artificiel est strict : il se nourrit exclusivement de La Phénoménologie de l’Esprit de Hegel… « Food for thought » [de la matière à penser] devient « thought for food » [des pensées à manger].
Les explorations en laboratoire d’Anna Dumitriu sur l’évolution synthétique et les acides aminés non canoniques se concentrent sur l’interaction entre la modélisation abstraite et le pliage en trois dimensions des acides aminés dans la recherche d’anticorps, tout en questionnant la terminologie biologique et les métaphores heuristiques, à l’image du cliché selon lequel toutes les formes de vie organique sont faites d’acides aminés formant un collier de perles. L’objet de la présentation et son mode de représentation deviennent dès lors identiques : dans Engineered Antibody, un collier en perles à taille humaine représente et contient physiquement les 21 acides aminés réels d’un anticorps. Dans Necklace, Dumitriu reconstitue et miniaturise la métaphore du « collier de perles » au niveau génomique : des séquences d’ADN artificiel, plasmides circulaires, sont à leur tour assimilées à des « colliers », mais « portées » cette fois à l’intérieur même de la bactérie.
Ce type de micro-sculptures évoque nombre de précurseurs historiques, et notamment les écrits de Jack Burnham sur « les effets de la science et de la technologie sur la sculpture de ce siècle »Burnham, Jack: Beyond Modern Sculpture. The Effects of Science and Technology on the Sculpture of this Century. New York, 1968.. Tenu en grande estime dans les milieux du media art, l’ouvrage Beyond Modern Sculpture est un incontournable malheureusement négligé dans les cercles classiques de l’histoire de l’art. Au moment même où Lucy Lippard diagnostique l’ère de la « dématérialisation de l’objet artistique »Lippard, Lucy R.: Six Years. The Dematerialization of the Art Object from 1966 to 1972. New York, 1973. en mettant l’accent sur les idées et les actions, Burnham offre une rétrospective biologiste et nourrie de l’histoire des technologies de plus de 2 500 ans de sculpture, faisant valoir que sa « survie » dépend de la transition qu’elle opère des objets matériels aux systèmes complexes : depuis les formes de vie imaginaires idéalistes jusqu’aux processus organicistes dans lesquels des macro-phénomènes du vivant sont expliqués par des micro-phénomènes sous-jacents, une transition « de la sculpture comme objet totémique chargé psychiquement à une adaptation plus littérale de la réalité scientifique via le modèle ou l’artefact inspiré de la technologie », et donc vers « des systèmes simulant la vie en utilisant la technologie »Burnham, ibid., p. 7.. Influencé par la cybernétique et la génétique moderne qu’elle a inspirée, mais aussi par des préoccupations environnementales, ainsi que par la biologie de Ludwig von Bertalanffy, Burnham appelle à un abandon de la forme et à une réorientation vers la fonctionnalité de la sculpture du futur, soit « un abandon des apparences biotiques, en faveur d’un fonctionnement biotique via la machine »Burnham, ibid., p. 76.. Il espère que les spectateurs de ce genre d’art seront ainsi incités à adopter une conscience environnementale planétaire holistique – non pas contra, mais qua la technologie :
« Si l’homme approche d’un moment de changement radical, non contrôlé par la sélection naturelle et la mutation, quel meilleur moyen non scientifique pour anticiper l’auto-re-création (et non la procréation) que l’activité spirituellement induite pour former artificiellement des images d’origine organique ? La sculpture moderne est-elle ce processus en très accéléré ? »Burnham, ibid., p. 374.
Dans ce contexte, il est facile de comprendre pourquoi Burnham est devenu l’initiateur de l’emblématique exposition Software, en 1970 à New York. Malgré les immenses progrès technologiques réalisés depuis cette époque, la plupart de ses parti-pris ont encore aujourd’hui une pertinence inattendue. Passant outre la distinction entre l’art et les autres pratiques culturelles profondément influencées par les nouvelles technologies de l’information, Burnham a également anticipé l’évolution générale de l’art vers des « préoccupations relatives aux systèmes naturels et artificiels, processus et relations écologiquesBurnham, Jack: Notes on art and information processing. Dans : Burnham, Software, ibid., p. 10.», en supposant que si « nous construisons des machines à notre image […], une séparation entre le corps et l’esprit ne peut être qu’une illusion nourrie de notre manque de connaissances scientifiques sur la biologie humaine et les systèmes de communication en général »Ibid., p. 11.. L’influence de la technologie du traitement de l’information – qui se développait alors rapidement – « sur des notions telles que la créativité, la perception et l’artIbid. » atteint un nouveau niveau avec les « machines humides » fabriquées par l’homme, et Burnham a d’ailleurs lui-même affirmé qu’en réalité « la séparation entre software and hardware se rapporte de manière tangible à notre propre anthropomorphismeIbid.», et qu’il convenait donc de la surmonter. Il a également souligné deux autres caractéristiques qui regagnent en pertinence avec le Wetware : « la tendance constante à la démocratisationIbid., p. 13. », puisque des technologies qui n’étaient accessibles qu’à une élite hautement qualifiée il y a vingt ans sont rapidement devenues des outils à la disposition de tous, mais aussi les défis mis au jour par de telles pratiques qui réactivent d’anciennes définitions de l’art, puisque « l’ars, au Moyen-Âge, était moins théorique que la scientia : il portait sur les compétences manuelles liées aux techniques ou à l’artisanat. Mais les distinctions actuelles entre beaux-arts, arts appliqués et arts scientifiques ont pris trop de proportions par rapport au schisme originel créé par la révolution industrielle ». Software n’opérait ainsi « aucune des distinctions qualitatives habituelles entre les sous-cultures artistiques et techniquesIbid., p. 14. ».
À la lumière de la récente tendance de la biologie Do It Yourself et de la vogue de la biologie de synthèse, il est surprenant de constater à quel point ces énoncés semblent visionnaires 45 ans plus tard – un temps presque incommensurable, voire une éternité, considéré à l’aune de la loi de Moore ! Selon les observations et prédictions de Gordon Moore, cofondateur d’Intel, dans les années 1960 et 1970, le nombre de transistors par puce, qui permet de faire baisser le prix du transistor et entraîne un véritable changement technologique, socioéconomique et, par conséquent, culturel, doublerait tous les deux ans environ. Il semblerait cependant que l’industrie du semi-conducteur ne soit plus aujourd’hui en mesure de tenir ces prédictionsMitchell, Waldrop M.: More Than Moore. In: Nature, Vol. 530, (11 février) 2016, p. 144-147. et que la « loi de Moore soit vraiment morte, cette foisBright, Peter: Moore’s law really is dead this time. Dans : Ars Technica, (11 février) 2016; http://arstechnica.com/information-technology/2016/02/moores-law-really-is-dead-this-time», notamment pour des questions de chaleur dans des puces toujours plus petites, mais aussi de phénomènes de physique quantique, la miniaturisation n’étant plus possible avec des matériaux conventionnels. Le wetware serait-il la solution ? Nombreux sont ceux qui anticipent les promesses inexplorées des fluides, de la chimie et du wetware – à base de cellules, d’ADN et de neurones – dans les nanotechnologies informatiques : « Ne vous occupez pas des tablettes. Attendez de voir des bulles et des moisissuresPopkin, Gabriel: Moore’s Law Is About to Get Weird. Never mind tablet computers. Wait till you see bubbles and slime mold. Dans : Nautilus, Issue 21, “Information. The Anatomy of Everything”, (12 février) 2015; http://nautil.us/issue/21/information/moores-law-is-about-to-get-weird! » En art, et dans toutes ses sous-cultures esthétiques et techniques, il est vraiment temps de se « mettre à jour » concernant le wetware.



